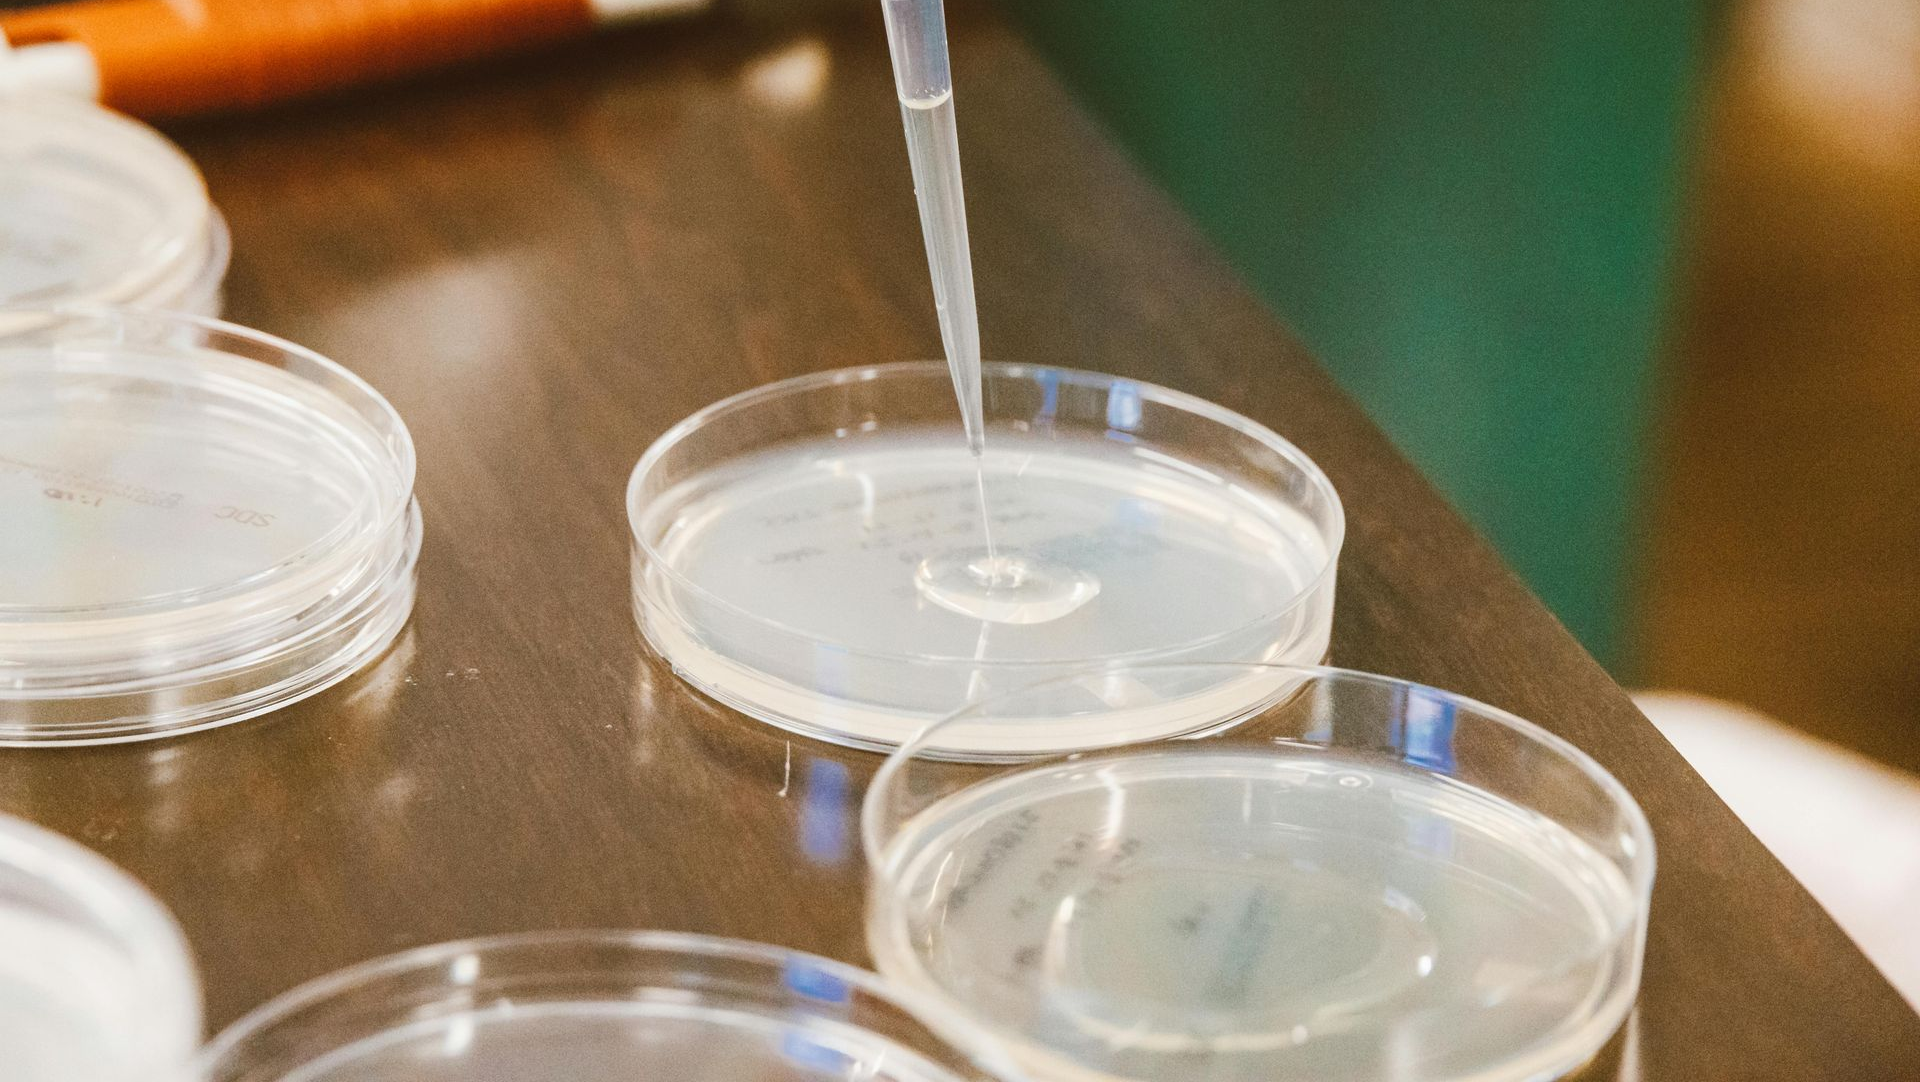
Pipette dispensing liquid into a petri dish on a wooden table. Other dishes and a dispenser are in the background.

How Tailored Cleaning Plans Benefit Specialized Facilities
Enhancing Safety and Compliance Through Specialized Facility Cleaning
Specialized facilities such as medical offices, laboratories, diagnostic centers, and treatment clinics require a level of cleaning that goes far beyond general office maintenance. These spaces operate with stricter hygiene expectations, more complex traffic patterns, and environments where contamination risks must be strictly controlled. A standard cleaning checklist is not sufficient for these settings. Instead, a customized cleaning plan is necessary to support compliance, safety, and operational efficiency. At ABS Facility Solutions, we design tailored cleaning programs that reflect the unique needs of each specialized facility and help create safer environments for patients, staff, and visitors.

Understanding the Unique Needs of Specialized Facilities
Medical offices and laboratories contain a wide range of sensitive areas, including exam rooms, waiting spaces, restrooms, diagnostic equipment zones, and staff workstations. Each area has its own cleaning requirements, frequency expectations, and risk considerations. A one size fits all approach cannot accommodate these differences.
For example, exam rooms require thorough disinfection after each patient visit, while administrative offices may only require routine dusting and trash removal. Laboratories may contain delicate equipment, chemical storage areas, and surfaces that must remain free of contaminants to maintain the integrity of testing processes. Tailored cleaning plans take these variations into account and ensure that each space receives the appropriate level of care.

Supporting Compliance and Industry Standards
Specialized facilities are held to higher standards due to the nature of their work. Regulatory expectations influence cleaning protocols, and failure to meet these standards may compromise patient safety and operational reliability. Tailored plans help ensure that cleaning routines align with current guidelines and support a safe environment for all occupants.
A specialized cleaning program outlines which disinfectants should be used, how frequently each space should be cleaned, and which procedures workers must follow. By using a structured approach, we help facilities maintain compliance and reduce the risk of issues related to inadequate sanitation or inconsistent cleaning practices.

Addressing High Touch and High Risk Areas
High touch surfaces such as doorknobs, light switches, chair arms, examination tables, and countertops require frequent attention. In specialized facilities, these areas may be used dozens or hundreds of times per day, which increases the potential for contamination. Tailored plans identify these surfaces and prioritize them in the cleaning routine.
High risk areas such as labs, sample handling stations, or treatment rooms require even greater attention. These spaces often require specialized disinfectants or techniques that reduce the risk of cross contamination. Our cleaning plans account for these needs and ensure that cleaning staff understand which products to use and how to apply them safely and effectively.
Customizing Frequency for Each Part of the Facility
Not all areas of a medical or laboratory facility require the same cleaning frequency. Waiting rooms and restrooms may need multiple cleanings per day, while storage areas may require less frequent attention. Tailored plans allow us to assign appropriate intervals for each task.
This approach ensures that resources are used effectively and that critical areas receive the necessary care. It also improves operational flow by reducing disruption. Cleaning tasks can be scheduled to avoid high traffic times or sensitive activities, allowing employees and patients to move through the facility with minimal interruption.
Protecting Equipment and Sensitive Materials
Medical and laboratory environments contain specialized equipment that requires careful handling. Some disinfectants and cleaning solutions may damage sensitive surfaces or electronic components. Tailored cleaning plans specify which products are safe to use and which should be avoided. This helps preserve equipment longevity and ensures that delicate instruments remain fully operational.
Additionally, certain areas may require controlled cleaning methods to avoid disturbing samples, chemicals, or archived materials. A customized plan ensures that cleaning staff have clear instructions and use methods that protect both equipment and data integrity.

Supporting a Safe and Comfortable Environment
A well maintained facility supports confidence and comfort for both patients and staff. Clean spaces reduce stress, improve first impressions, and contribute to a sense of professionalism. Tailored cleaning plans support this by ensuring that every area receives the attention it requires.
At ABS Facility Solutions, we develop cleaning plans that reflect the unique operations of each specialized facility. By focusing on compliance, safety, and the practical needs of each space, we help create healthier environments that support the daily work of medical and laboratory professionals.
Delivering Care Through Customized Support
Specialized facilities deserve cleaning programs designed to match their complexity and sensitivity. Through tailored cleaning plans, we provide comprehensive, thoughtful care that protects equipment, supports compliance, and enhances the well being of everyone who enters the space. Our goal is to deliver consistent, high quality cleaning solutions that help specialized facilities operate with confidence and clarity.










